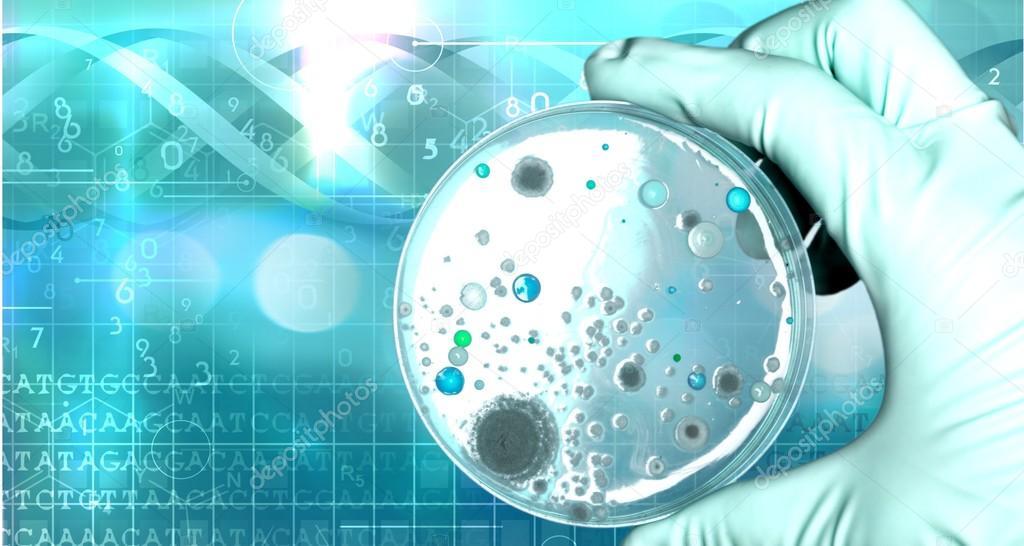
몸의 지배자_몸속 미생물 숫자.jpg

[운동 안내서] 내 몸속 우주 : 미생물과의 공생
몸은 혼자 살지 않는다
우리는 개별적 존재처럼 느껴지지만, 몸은 미생물과 함께 하나의 생태계를 이룬다. 그들에게 있어 우리는 단순한 인간 종이 아니라, 풍성한 생태계로 이루어진 거대한 움직이는 세계이다(우주적 관점에서 보면 지구는 그저 원자 속 전자에 지나지 않는 것처럼 말이다). 몸속 미시세계에서 살아가는 단세포생물들은 몸 구석구석 엄청난 수가 살고 있으며 건강의 모든 측면, 심지어 우리의 성격까지 상상을 초월할 정도로 막강한 영향을 미친다.
이 작은 생명체들은 그저 잠시 머물렀다가 떠나는 존재가 아니라 가장 기본적인 생명 과정, 즉 소화와 면역 반응, 심지어 행동에 이르기까지 결정적인 역할을 수행한다. 사실 매 순간 우리는 이 엄청난 미생물 공동체와 조화를 이루며 살아간다. 당신이 이 글을 읽고 있을 이 순간, 몸속과 피부 위를 터전 삼아 살아가는 미생물은 약 4만 종에 달한다. 그 숫자는 연구가 진행됨에 따라 늘어날 것이다(2019년에는 장 속 미생물 105종이 처음 발견되기도 했다).
콧구멍에 900종, 뺨 안에 800여 종, 잇몸에 1,300여 종, 소화관에는 약 3만 6,000종이 있다. 정확한 종의 수는 사람마다 그리고 아기인가 노인인가, 남성인가 여성인가, 운동을 하는가 하지 않는가, 식단의 구성 형태 그리고 종종 단식을 하는가 하지 않는가, 단순 감기에 항생제를 썼는가 아닌가, 마르거나 비만인가 등에 따라 시간이 흐르면서 달라진다.
물론 이 숫자는 종의 수만 가리키며 미생물의 수를 따지자면 상상할 수 없을 만큼 많다. 얼마나 많을까? 1972년 발표된 논문에는 약 100조 개로 추정했다. 대변 1그램에 1,000억 개 미생물이 존재한다는 보고, 1리터 부피에 달하는 인간 장내에 있는 미생물의 총수를 1014 자릿수 규모로 추산한 것이다.
 사람의 몸은 혼자 살지 않는다. 약 39조 개의 미생물과 공생을 하고 있다. [이미지 출처: 구글]
사람의 몸은 혼자 살지 않는다. 약 39조 개의 미생물과 공생을 하고 있다. [이미지 출처: 구글]하지만 2016년 발표된 논문에서는 인간의 몸속 미생물은 약 39조 개로 추정했다. 37조 개의 세포와 엇비슷한 규모다.[1] 무게로 따지면 약 1.5kg에 달하며, 뇌 무게와 비슷하다. 크기는 거대한 세포에 비해 미생물은 매우 작다. 각기 다른 연구 결과와 상관없이 몸은 세포들과 미생물들이 공생하는 하나의 생태계라고 할 수 있다. 세포공생설의 마굴리스는 “모든 생명체는 공생하는 세균들의 연합으로 이루어진 작은 우주다.”라고 했다. 이 견해의 기원은 다윈의 유명한 구절로 거슬러 올라간다.
모든 생명체는 저마다 하나의 작은 우주다. 이 작은 우주는 자가번식하는 유기체들로 이루어져 있다. 이 유기체는 상상할 수 없을 정도로 작고 하늘의 별만큼이나 많다.
우리 몸속 미시세계
몸속에 존재하는 미시세계야말로 질병과 정신적ㆍ육체적 건강 그리고 우리 자신을 이해하는 방식을 송두리째 바꿔버릴 만한 잠재력이 있다. 우리 주위에는 놀라울 만치 다양한 미생물이 있으며, 그들이 좋든 나쁘든 간에 우리에게 어떤 영향을 미치는지를 이해하는 일을 이제 겨우 시작한 상황이다.
그리고 우리 몸을 생태계로 인식하는 일은 매우 중요하다(하지만 몸이 생태계란 것을 인식하지 못한 채, 자기 몸을 스스로 망치는 이들이 얼마나 많은가. 마치 우리가 지구 생태계의 일원인 것을 망각한 채 지구 환경을 파괴하는 것처럼 말이다).
어쩌다 우리는 미생물과 함께 살게 되었을까? 이와 관련해서는 <세상의 숨은 지배자>에서 다루니 요약하면 이렇다. 단세포였던 공통 조상 루카로부터 다세포를 비롯해 다양한 생명체로 진화하는 과정은 경쟁이 아니라 공생에 따라 진행되었다는 진핵세포의 ‘공생설(Endosymbiosis, 공생진화론)’에 답이 있다.
공생설에 따르면 인간을 비롯한 모든 동물ㆍ식물ㆍ곰팡이가 하나의 독립된 생명체로 지구에 나타난 것이 아니라 먼 과거에 세균의 일종인 다른 생명체와 공생체를 형성했다는 것이다. 수십 억 년 전 우리 조상 세포 안으로 들어온 미생물의 유전자가 지금까지도 미토콘드리아 안에 남아 있는데, 이를 해독해보니 대장 속에서 발견되는 대장균의 먼 친척으로 보인다.
유전자 관점에서 보면 몸속 세포에는 약 2만 개의 유전자가 있지, 미생물의 유전자는 무려 200만에서 2,000만 개에 달한다. 결국 우리는 인간이라기보다 99% 미생물이며, 나라는 존재는 겨우 1%에 불과한 셈이다. 몸속에 너무나 많은 미생물이 존재하기에 그 다양한 유전자를 모두 합하면 인간의 유전자를 압도함은 틀림없는 사실이다.[2]
이는 시작에 불과하다. 우리 몸속과 표면에 사는 미생물은 사람마다 각양각색이다. 인간 DNA라는 측면에서 볼 때 모든 인간은 같다고들 한다. 인간은 서로 99.99퍼센트 동일한 DNA를 갖고 있다. 하지만 장내 미생물이라는 관점에서 보면 사정이 전혀 다르다. 우리는 서로 채 10%조차 일치하지 않을 수도 있다. 이러한 차이를 이용하여 체중에서 알레르기까지, 어떤 병을 앓게 될 가능성부터 특정 상황에서 얼마나 불안을 느끼는지에 이르기까지 엄청난 다양성을 설명할 수 있을지도 모른다.
우리는 이렇게 광대한 현미경적 세계를 탐사하고 이해하는 데 이제 막 첫발을 뗐을 뿐이지만, 지금까지 발견한 것만으로도 그 의미는 가히 충격적이다. 불과 40년 전만 해도 우리 몸속에 얼마나 많은 단세포생물들이 존재하는지, 종류는 얼마나 되는지 전혀 몰랐다는 데 생각이 미치면 미생물 세계의 놀라운 다양성에 정신이 아득해질 정도다.
- 롭 라이트 & 브랜던 블러의《내 몸속의 우주》중에서[3]
생애 첫 미생물 생태계 형성
그런데 미토콘드리아의 조상은 왜 자기 삶을 버리고 다른 생명체의 안으로 들어왔을까? 하나의 세포 안에는 미토콘드리아가 약 100개에서 3000개 정도가 존재한다. 이 미토콘드리아의 역할을 알면 공생의 이유를 알 수 있다. 자세한 얘기는 <세상의 숨은 지배자>에서 다루기로 하고, 몸속 미시세계 이야기를 이어가자. 몸속 생태계가 만들어지는 과정이 기억나지 않겠지만, 엄마 배 속에 있던 시절로 돌아가 보자.
태반은 무균 상태이지만 태아는 태어나면서 미생물과 접촉하며 세상을 맞이한다. [이미지 출처: 구글]
태반은 무균 상태이지만 태아는 태어나면서 미생물과 접촉하며 세상을 맞이한다. [이미지 출처: 구글]자궁 내벽에 있는 건강한 태반은[4] 본질적으로 무균 상태이며, 세균이 없는 태아는 출생 시 엄마에게서 미생물을 물려받는다.[5] (제왕절개가 아닌 자연분만으로) 태어나면서 엄마의 질 속 미생물을 받으며, 이후 모유를 비롯한 음식물과 주변 환경으로부터 다양한 미생물이 장으로 들어오면서 생애 첫 미생물 생태계를 형성한다.
특히 태아부터 유아기까지 먹는 것이 건강에 큰 영향을 미치는데, 이 첫 번째 미생물 생태계가 제대로 구성되지 않으면 이후 아토피ㆍ천식ㆍ자폐ㆍ비만 등이 확률이 높아진다. 모유를 먹은 아기는 모유 속에 존재하는 특수한 미생물은 물론, 유익한 미생물의 성장을 촉진하는 특수한 당류에 노출된다. 어렸을 때 다양한 미생물에 노출된 아이들, 예컨대 집안에 형제자매나 반려동물이 있거나 시골에 사는 아이는 도시에서 자란 아이에 비해 아토피, 천식 등 면역 질환 발생률이 더 낮은 경향이 있다.
그리고 출생 전 및 생후 첫해에 반려동물에 노출되면 알레르기 발생 위험이 감소하는 듯하다. 놀랍게도 개를 키우는 부부의 경우 그들 몸속 미생물의 다양성이 증가했다.[6] 따라서 아기에게 좋은 미생물 생태계를 만들어 주려면 평상시 부부가 건강한 식단ㆍ규칙적인 운동ㆍ건강한 생활습관을 유지하는 것이 중요하다. 더 기쁜 소식은 “운동만 해도 장 속 유익한 미생물들 쑥↑ 실험으로 확인돼”었다는 사실이다.[7]
원문: <[운동 안내서] 내 몸속 우주 : 미생물과의 공생>
■ 다음 연재 글:
[1부 – 안내서에 대한 안내서: 움직인다는 것] 1장. 움직인다는 것_태초에 움직임이 있었으니
몸의 지배자: 무엇이 우리 몸을 지배하는가?
• '제2의 뇌'로 불리는 그들
■ 함께 읽으면 좋은 글
[운동 안내서] 삶을 변화시키는 힘! 운동이란 무엇인가?
[운동 안내서] 우리는 무엇인가? | "예전보다 운동을 많이 합니다"
[심플 운동] #살아있다 하여 비울 것 그리고 채울 것!
[완벽한 몸만들기] 17년 만에 다시 쓰는 몸만들기와 운동 이야기
[완벽한 몸만들기] 몸만들기와 모든 운동 시작 전 꼭 알아야 할 사항들
[운동 안내서] 무한한 춤을 추는 세포 당신 몸속 작은 우주 이야기: 37조 개 움직임과의 만남
참고 문헌
[1] <“인체 박테리아 수 100조? 40여년 전 부정확한 어림셈”> 사이언스온, 2016.1.12
[2] p14, 전자책, 롭 나이트 & 브랜던 불러의《내 몸속의 우주》
[3] P11, 전자책, 롭 나이트 & 브랜던 블러의《내 몸속의 우주》
[4] 저자 주: 태반이란 임신 후 모체의 자궁 내벽에 생기는 장기로서, 태아와 탯줄로 연결된다. 태반은 기본적으로 모체와 태아 사이에서 태아의 생존과 성장에 필요한 물질교환을 매개하는 기능을 담당한다.
[5] “건강한 자궁은 『무균실』 맞다” - Bric, 2019.8.1
[6] p27, 전자책, 롭 나이트 & 브랜던 불러의《내 몸속의 우주》
[7] <”운동만 해도 장 속 유익한 미생물들 쑥↑ 실험으로 확인돼”> 연합뉴스, 2017.12.6
By 푸샵 이종구: <남자들의 몸 만들기, 2004> 저자
·자격사항: 개인/임상/재활 운동사, 미국체력관리학회 공인 퍼스널 트레이너(NSCA-CPT), NSCA-스포츠영양코치, 국가공인 생활스포츠지도사2급, 퍼스널 트레이너2급, 웃음치료사2급, 바디테크닉 수료
·사이트&SNS: http://푸샵.com, 페이스북, 인스타그램